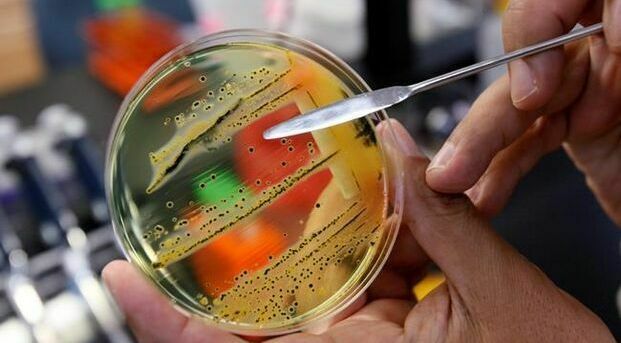

ब्रैम्पटन हिंदू मंदिर हिंसा में भारत की सख्ती का असर, एक पुलिस अधिकारी निलंबित
चंद्र प्रकाश चौरसिया ब्रैम्पटन: कैनेडा के ब्रैम्पटन में हिंदू सभा मंदिर में हुई हिंसा को लेकर भारत सरकार ...
अधिक पढ़ें.. भूकंप के तेज झटके से दहला कैनेडा का ब्रिटिश कोलंबिया, दहशत में लोग
चन्द्र प्रकाश चौरसिया ओटावा: कैनेडा के ब्रिटिश कोलंबिया के तटीय शहर पोर्ट मैकनील में रविवार को दोपहर भूकंप ...
अधिक पढ़ें.. ओंटारियो में बनेगा कैनेडा का सबसे बड़ा अस्पताल !
टोरंटो, 2 दिसंबर। सरकारी सूत्रों का कहना है कि ओंटारियो प्रीमियर डग फोर्ड और स्वास्थ्य मंत्री ...
अधिक पढ़ें.. कैनेडा में बर्फबारी की मार, शून्य से नीचे पहुंचा तापमान, कई जगह स्कूल कॉलेज बंद
टोरंटो,2 दिसंबर। कैनेडा में सर्दियों तथा वर्ष बारिश का मौसम शुरू हो गया है। क्रिसमस से ...
अधिक पढ़ें.. टोरंटो में बुधवार तड़के हुई गोलीबारी में दो लोग गंभीर रूप से घायल
टोरंटो, 24 नवंबर। बुधवार तड़के टोरंटो के सेंटर फॉर एडिक्शन एंड मेंटल हेल्थ के मैदान के ...
अधिक पढ़ें.. चाइल्ड केयर शुल्क में कटौती को लेकर ओंटारियो तथा ओटावा की महत्वपूर्ण बैठक आज
टोरंटो, 24 नवंबर। ओंटारियो के शिक्षा मंत्री का कहना है कि प्रांत चाइल्ड केयर कार्यक्रमों संबंधी ...
अधिक पढ़ें.. ओंटारियो की कंजरवेटिव सरकार तोड़ रही विज्ञापनों पर महालेखा परीक्षक की शक्तियों संबंधी चुनावी वादा
टोरंटो, 22 नवंबर। ओंटारियो की प्रगतिशील रूढ़िवादी सरकार सरकारी विज्ञापनों पर महालेखा परीक्षक की शक्तियों को ...
अधिक पढ़ें.. कोविड-19 संक्रमित कैनेडियन सीनेटर का अस्पताल में निधन, ट्रूडो ने जताया शोक
टोरंटो, 21 नवंबर। वकील और ओंटारियो की सीनेटर जोसी फ़ॉरेस्ट-निसिंग का कोविड-19 संक्रमित होने पर अस्पताल ...
अधिक पढ़ें.. कैनेडा की स्वास्थ्य एजेंसी कर रही सालमोनेला से जुड़े मामलों की जांच
ओटावा,13 नवंबर। कैनेडा की सार्वजनिक स्वास्थ्य एजेंसी का कहना है कि वह पश्चिमी कैनेडा में साल्मोनेला ...
अधिक पढ़ें.. कैनेडा में बच्चों के लिए वैक्सीन का निर्णय आगामी एक-दो सप्ताह में
टोरंटो, 13 नवंबर। हेल्थ कैनेडा ने कहा है कि बच्चों के लिए कैनेडा-19 वैक्सीन को अधिकृत ...
अधिक पढ़ें.. 200 तक पहुंच सकती है आईसीयू में भर्ती कोविड-19 संक्रमितों की संख्या
टोरंटो, 13 नवंबर। ओंटारियो में अधिकांश सार्वजनिक स्वास्थ्य इकाइयों में कोविड-19 मामलों में वृद्धि देखी जा ...
अधिक पढ़ें..